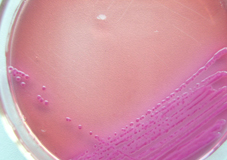

海博微信公众号
海博微信公众号
 海博天猫旗舰店
海博天猫旗舰店


 海博微信公众号
海博微信公众号
 海博天猫旗舰店
海博天猫旗舰店




大肠菌群是只一群能发酵乳糖、产酸、产气、需氧和兼性厌氧的革兰氏无芽孢杆菌 。该菌主要来源于人畜粪便。
检测该菌的方法主要有MPN法,平板计数法等
MPN法中主要用到的是LST、BGLB、EC肉汤等
平板计数法主要用DC、VRBA等。
在检测该菌时易出现的问题:
1、 LST、BGLB、EC等在灭菌时小倒管中气泡排不尽。
2、 气泡不易观察。
3、 VRBA、DC平板上菌落特征不易辨认。
原因:1、在分装LST、BGLB、EC时,小倒管中有水柱;此外,高压灭菌后,需急排气,然后迅速冷却。
2、观察气泡时,要对光倾斜试管观察。
1、 熟悉大肠杆、大肠菌群在上述平板上的特征,必要可做一些阳性的对照。有些食物残渣会影响观察结果,这样需要我们在培养前仔细观察平板的状态,大的食物残渣可以做一些标记。
检测该菌的方法主要有MPN法,平板计数法等
MPN法中主要用到的是LST、BGLB、EC肉汤等
平板计数法主要用DC、VRBA等。
在检测该菌时易出现的问题:
1、 LST、BGLB、EC等在灭菌时小倒管中气泡排不尽。
2、 气泡不易观察。
3、 VRBA、DC平板上菌落特征不易辨认。
原因:1、在分装LST、BGLB、EC时,小倒管中有水柱;此外,高压灭菌后,需急排气,然后迅速冷却。
2、观察气泡时,要对光倾斜试管观察。
1、 熟悉大肠杆、大肠菌群在上述平板上的特征,必要可做一些阳性的对照。有些食物残渣会影响观察结果,这样需要我们在培养前仔细观察平板的状态,大的食物残渣可以做一些标记。

上一篇:微生物培养基效期的分类
下一篇:金黄色葡萄球菌检测注意事项



